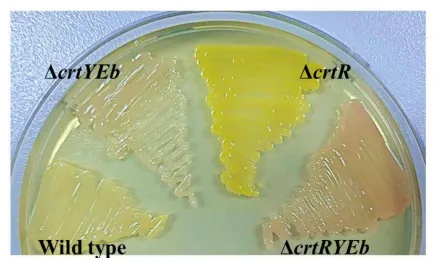

요약
본 발명은 카로티노이드의 중요성을 바탕으로, 특히 항산화 활성이 뛰어난 C50 카로티노이드인 박테리오루베린의 대량 생산을 위한 새로운 방법을 제시합니다. Corynebacterium glutamicum 균주를 활용하여 유전자 변형을 통해 카로테노이드 생산을 극대화하는 기술을 개발하였습니다. 이 기술은 코돈 최적화와 전기천공법을 통해 재조합 균주를 생성하고, CGXII 최소 배지에서의 배양을 통해 효율적으로 박테리오루베린을 생산합니다. 실험 결과, 재조합 균주는 성공적으로 박테리오루베린을 생산하였으며, 연속식 배치 발효 실험을 통해 생산의 재현성을 확인하였습니다. 이 발명은 식품, 의약품, 화장품 산업 등 다양한 분야에서 천연 색소 및 항산화제로서의 활용 가능성을 제공하며, 기존 방식에 비해 비용 절감과 생산 효율성을 향상시켜 카로테노이드 산업의 기술적 혁신을 선도할 것으로 기대됩니다.
기본 정보
•
특허명: C50 카로티노이드 생산능을 갖는 코리네박테리움 글루타미컴 재조합 균주 및 이를 이용한 C50 카로티노이드 생산방법
•
대표 발명자: 서명지 교수
•
출원번호: 10-2023-0117193
발명의 배경 및 필요성
카로티노이드의 중요성
•
카로티노이드는 600종 이상의 천연 색소로, 식물, 조류, 광합성 박테리아가 합성하며 일부 비광합성 박테리아와 효모에서도 발견됨
•
이 색소들은 과일과 채소의 색을 결정하고, 광합성에 필수적이며, 인간 영양에서 비타민 A의 전구체로서 중요한 역할을 함
•
항산화 특성으로 인해 세포를 산화적 손상으로부터 보호하고, 만성 질환 예방에 기여함
카로티노이드의 산업적 응용과 연구 필요성
•
식품 색소, 동물 사료, 화장품, 건강 보조 식품 등 다양한 산업 분야에서 카로티노이드의 생산이 점차 중요해지고 있음
•
지속 가능하고 비용 효율적인 생산을 위해 유전자 변형 미생물과 발효 공정의 사용이 탐색되고 있음
•
특히 C50 카로티노이드인 박테리오루베린은 독특한 특성을 가지고 강한 항산화 활성을 보여 극한 환경에서 미생물을 보호하는 역할을 함
•
라이코펜과 같은 카로티노이드는 특정 암과 심혈관 질환의 위험 감소와 관련된 연구가 활발히 진행 중임
•
농업, 영양학, 의학, 생명공학 분야를 아우르는 카로티노이드 연구는 새로운 생명공학적 생산 방법 개발과 인간 건강에 대한 잠재력을 활용하는 데 기여할 수 있음
구현방법
기술의 원리 및 구현
•
Corynebacterium glutamicum을 활용하여 C50 카로테노이드를 생산하며, Haloferax marinum MBLA0078T에서 유래한 카로테노이드 생합성 유전자를 포함한 재조합 벡터를 개발함
•
코돈 최적화를 통해 유전자 발현을 효율적으로 조정함
•
재조합 균주를 생성하고 CGXII 최소 배지에서 배양하여 C50 카로테노이드를 생산함
•
전기천공법으로 재조합 벡터를 숙주 세포에 도입하고, 항생제를 포함한 배지에서 변형된 균주를 선별함
•
박테리오루베린 생합성 유전자를 과발현시켜 생산량을 증가시키고, 발효 과정을 거쳐 카로테노이드를 추출 및 분석함
기술의 장점
•
기존 방법 대비 효율적인 카로테노이드 생산 방법을 개발하고, C50 카로테노이드의 대량 생산이 가능한 Corynebacterium glutamicum 균주를 구축함
•
발효 과정의 최적화를 통해 생산 수율을 높임
실험 및 결과
실험 목적 및 방법
•
Corynebacterium glutamicum을 이용한 카로테노이드 생산 가능성을 탐구하고, 재조합 균주의 효과적인 생산을 확인함
•
PCR 기법으로 특정 유전자를 복제하고 재도입하며, 발효 과정에서 적절한 영양분 공급과 환경 조건을 유지함
•
전기천공법으로 재조합 벡터를 숙주 세포에 도입하고, 항생제가 함유된 배지에서 변형된 균주를 선별함
•
추출된 카로테노이드는 아스코르브산으로 산화를 방지하고, 특수 장비로 분석함
실험 결과
•
재조합 균주를 이용해 박테리오루베린과 그 이성체, 전구체를 성공적으로 생산함
•
발효 실험을 통해 균주의 성장과 박테리오루베린의 축적이 시간에 따라 증가하는 경향을 확인함
•
5L 규모의 연속식 배치 발효 실험으로 박테리오루베린 생산의 재현성을 두 번 확인함
발명의 활용 방안
다양한 산업 분야에서의 활용
•
식품 산업에서 천연 색소로 활용되는 카로테노이드 생산에 적용
•
의약품 산업에서 항산화제 및 비타민 A 전구체로서 카로테노이드 개발에 활용
•
화장품 산업에서 피부 건강과 면역 기능 강화 성분으로 카로테노이드 사용
경제적 및 기술적 이점
•
기존 방식 대비 비용 절감과 생산 효율성 향상을 이룬 카로테노이드 생산 방법
•
재조합 미생물을 통한 C50 카로테노이드의 고효율 생산으로 산업적 응용 가능성 확대
•
발효 공정을 통해 대량 생산이 가능하여 제품의 상업적 가치와 시장 접근성 향상
발명의 기대효과
혁신적 기술 발전
•
비자연적인 박테리오루베린 축적을 증명하여 생명공학 연구에 새로운 장을 열음
•
발효 과정을 이용한 고수율 생산으로 카로테노이드 산업의 기술적 혁신 선도
시장 경쟁력 및 사회적 기여
•
효율적인 생산 방법으로 건강 식품 및 화장품 산업의 경쟁력 향상 기대
•
카로테노이드의 건강상 이점에 대한 사회적 수요 충족 가능
•
환경 친화적인 천연 색소 대량 생산으로 지속 가능한 생산 및 소비 기여 예상
시장 동향
식품 산업 시장 동향
기술 SWOT 분석
Strengths
독특한 C50 카로테노이드 생산
•
Corynebacterium glutamicum을 활용하여 특수한 C50 카로테노이드인 박테리오루베린을 생산합니다.
생산 효율성
•
코돈 최적화와 재조합 벡터 개발을 통해 카로테노이드의 생산 효율성을 높였습니다.
다양한 산업 분야 적용 가능
•
식품, 의약품, 화장품 산업 등 다양한 분야에서 천연 색소로 활용될 수 있습니다.
Weaknesses
생산 과정의 복잡성
•
재조합 균주의 생성과 발효 과정이 복잡하여 생산 과정에 전문성이 요구됩니다.
균주의 안정성 관리
•
변형된 균주의 유지와 안정성 관리가 필요하여 지속적인 모니터링이 요구됩니다.
Opportunities
건강 식품 및 화장품 산업의 수요 증가
•
카로테노이드의 건강상 이점에 대한 인식이 높아지면서 관련 산업의 수요가 증가하고 있습니다.
환경 친화적인 생산 방법
•
지속 가능하고 환경 친화적인 생산 방법으로 시장에서의 선호도가 높아질 수 있습니다.
Threats
기존 카로테노이드 생산 방법과의 경쟁
•
기존의 화학적 합성 방법이나 다른 생물학적 방법과의 경쟁에서 우위를 점해야 합니다.
규제 및 허가 절차
•
유전자 변형 미생물을 이용한 생산 방법은 규제 및 허가 절차가 엄격할 수 있습니다.
Summary
Strengths
•
독특한 C50 카로테노이드 생산 기술과 효율적인 생산 방법으로 다양한 산업 분야에 적용 가능합니다.
Weaknesses
•
생산 과정의 복잡성과 균주의 안정성 관리가 필요합니다.
Opportunities
•
건강 식품 및 화장품 산업의 수요 증가와 환경 친화적인 생산 방법으로 시장 기회가 확대됩니다.
Threats
•
기존 생산 방법과의 경쟁과 규제 및 허가 절차의 어려움이 존재합니다.
대표도면
인천대학교 산학협력단
(21999) 인천광역시 연수구 갯벌로 27(송도동) INU이노베이션센터 202호
본 메일은 마케팅 활용 동의서에 동의하신 회원님께 전송된 것입니다.
COPYRIGHT (c) 2023 Incheon National University. ALL RIGHT RESERVED.